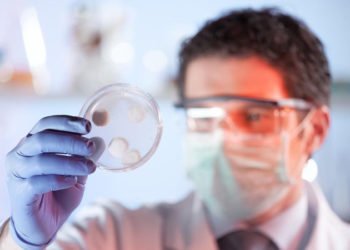
Razvili virus koji ubija stanice raka – i uništava im skrovišta

Reportaža iz sablasno pustog Međugorja: U svetištu šačica Talijana, poduzetnici ogorčeni ‘pompom’ oko virusa kažu da je i u ratu bilo više gostiju
Hercegovačko svetište Kraljice mira koje je u doba korizme vrvilo hodočasnicima sablasno je prazno. Puste su ulice, dućani, kafići i ...
OpširnijeDetails